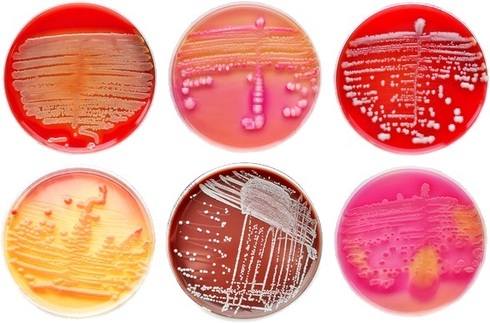
Θρεπτικά Υλικά του οίκου Bioprepare

Θρεπτικά Υλικά
Τα θρεπτικά υλικά χρησιμοποιούνται από την Ιατρική Μικροβιολογία για την απομόνωση και ταυτοποίηση μικροβίων που προσβάλλουν τον ανθρώπινο οργανισμό. Αποτελούνται από θρεπτικά συστατικά και από μη θρεπτικά στοιχεία και διαχωρίζονται ανάλογα με τη σύστασή τους σε: κοινά, εμπλουτισμένα, εκλεκτικά, διαχωριστικά, συνθετικά ή εμπειρικά θρεπτικά υποστρώματα.
Είναι κατασκευασμένα από υψηλής ποιότητας πρώτες ύλες και παραγωγικό εξοπλισμό προηγμένης τεχνολογίας με αυστηρές προδιαγραφές ποιοτικού ελέγχου.
Διατίθεναι επίσης κοινά θρεπτικά υλικά για πληθώρα κλινικών εφαρμογών καθώς και χρωμογόνα υλικά τα οποία επιτρέπουν τη χρωματική διαφοροποίηση, απομόνωση και ταυτοποίηση αερόβιων και αναερόβιων βακτηρίων καθώς και μυκήτων, τα οποία διαχωρίζουν τα βακτήρια και τους μύκητες βάσει των ενζύμων τους. Η απομόνωση των βακτηρίων γίνεται πολύ πιο εύκολα και αξιόπιστα λόγω των χρωμογόνων ουσιών που περιέχονται στα υλικά αυτά.
Χρωμογόνα θρεπτικά υλικά
Νέας γενιάς υλικά τα οποία διαχώριζουν τα βακτήρια και τους μύκητες βάση των ενζύμων τους. Οι χρωμογόνες ουσίες των υλικών αυτών χρωματίζουν τις αποικίες αρκετών βακτηρίων με διάφορα χρώματα και τα απομονώνουμε πολύ καλύτερα απ΄ ότι στα κοινά θρεπτικά υλικά.